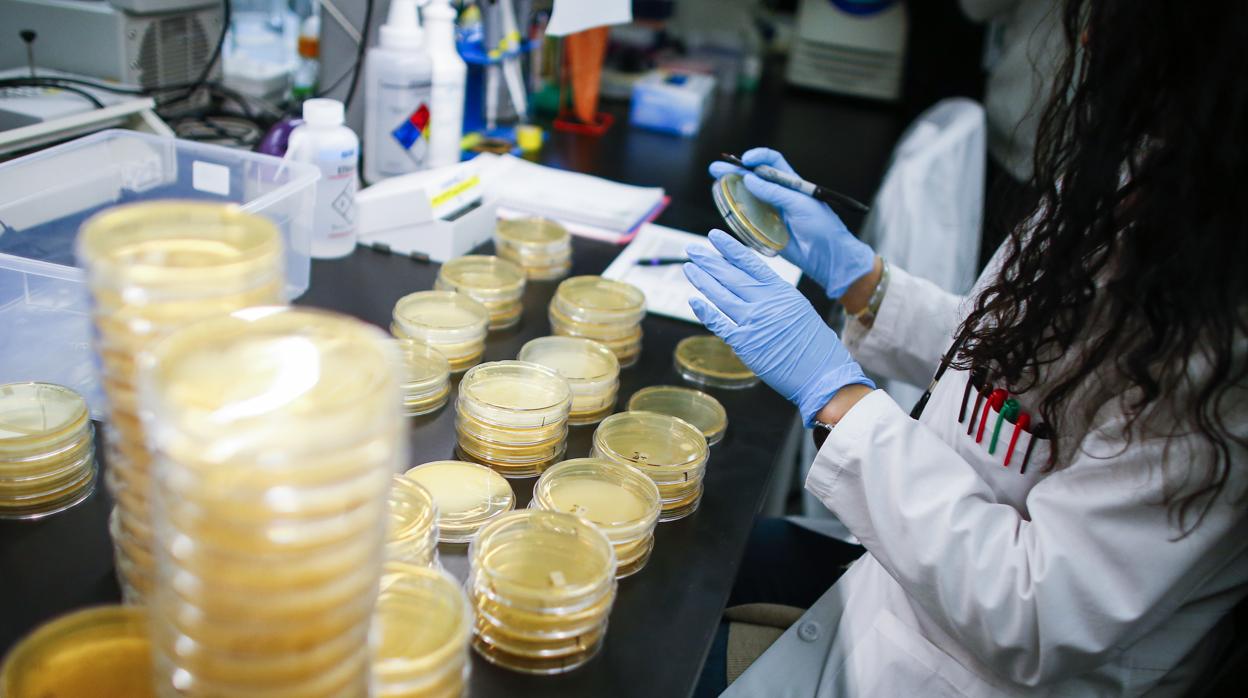
Una sanitaria comprueba los análisis hechos para detectar el coronavirus

El coronavirus en Sevilla: conexión asiática vía Málaga
Un médico que trató a Miguel Ángel Benítez, el primer infectado de la comunidad, es el segundo caso de la capital hispalense; Andalucía cuenta con ocho positivos
El sevillano con coronavirus: «No estoy asustado, los médicos me transmiten mucha tranquilidad»
M. Benítez / J. Díaz / R. Román
Los casos positivos en coronavirus se han ido multiplicando en todo el mundo en las últimas horas, de ahí que resultara extraño que en Andalucía , un lugar muy turístico, sólo hubiera un infectado. Pues bien, ayer todo dio un vuelco significativo, porque ... la comunidad cuenta ya con ocho personas que han dado positivo en los análisis de Covid-19 . Eso sí, algunos de ellos sirvieron para conocer que Miguel Ángel Benítez , el sevillano que parecía ser el primer caso local de España, fue infectado por un compañero de trabajo de Málaga . Y también para saber que un médico que lo había tratado también ha dado positivo.
Y es que la jornada estuvo llena de noticias en relación a esta enfermedad que tiene en alerta a gran parte del mundo. En Andalucía, hasta ayer al mediodía, sólo había un caso positivo, el de un sevillano de 62 años que se encuentra aislado en el hospital Virgen del Rocío. Y, aunque el consejero de Salud aportó algunos datos en una entrevista con motivo del Día de Andalucía, no fue hasta más tarde cuando se aclararía todo este asunto.
Según pudo saber ABC, el primer caso en Andalucía, que se está sometiendo a un tratamiento experimental, se contagió a través de un compañero de trabajo cuando acudió hace unas tres semanas a Málaga para una convención de la entidad bancaria en la que desarrolla su labor profesional. Resulta que en dicho evento estuvo con un trabajador residente en la Costa del Sol que había tenido contacto en Marbella, unos días antes, con personas de origen asiático . A la convención, según las fuentes consultadas por este periódico, este hombre de 42 años habría llegado con evidentes síntomas de malestar, muchos de los cuales coincidirían con los del coronavirus. Y ayer se hizo oficial que en Málaga aparecían cuatro casos positivos. Uno de ellos, el del compañero de Miguel Ángel.
De este modo, se acababan con las especulaciones sobre cómo se había contagiado este sevillano que ya había explicado a ABC que sólo se le ocurría la vía de Málaga como opción para tener coronavirus. Pero este caso todavía dio para más porque, como es evidente, ahora se han multiplicado las pruebas a las personas que han tenido contacto con Miguel Ángel desde que comenzó a tener síntomas hace dos semanas. Y, por lo pronto, uno de esos análisis ha dado positivo. Se trata de un médico sevillano, de 58 años , que tuvo contacto con este primer paciente confirmado en Andalucía y se encuentra en seguimiento activo en su domicilio con todas las garantías de seguridad y atención, tal y como dictaminan los protocolos del Ministerio de Sanidad para estos casos. La Consejería de Salud ya había comunicado que estaban estudiando algunos casos sospechosos y que podrían aparecer algunos positivos. Como así ocurrió y puede seguir ocurriendo en este caso que tiene la conexión Asia-Málaga-Sevilla. De hecho, este médico que ha sido infectado ahora es sólo uno de los 69 que ha tratado durante estos días a Miguel Ángel Benítez y que, desde el jueves, están en casa a la espera de resultados y de ver qué síntomas presentan.
Más positivos en Andalucía
Al cierre de esta edición, los positivos en coronavirus en Andalucía habían pasado del único que había el jueves a los ochos que hay este sábad o. Y es Málaga la provincia que cuenta con más personas infectadas . Fue el director del Centro de Coordinación de Alertas y Emergencias Sanitarias del Ministerio de Sanidad, Fernando Simón, el primero en anunciar que los casos confirmados por coronavirus ascendían, al mediodía, a seis, todos ellos importados.
Uno de los cinco nuevos confirmados era un paciente de 28 años ingresado en el Hospital Mediterráneo de Almería y residente en Milán. Por otro lado, había tres casos en Marbella que están relacionados con el primer paciente confirmado en Andalucía. Son dos varones de 42 y 53 años, respectivamente. Uno de ellos, el compañero de trabajo del primer infectado de Sevilla , había referido contacto con ciudadanos de origen asiático no residentes en España. Y a estos se suma una paciente de 81 años, con vinculación familiar con uno de los dos casos anteriores. El quinto de esos nuevos casos fue una paciente de 55 años que ha viajado recientemente a la ciudad italiana de Emilia-Romagna y que reside en Fuengirol a.
Y ya antes de la noche, aparte de notificarse el positivo del médico que había tratado al primer infectado de Sevilla, la Junta explicaba el caso de una enfermera de Arjonilla (Jaén), de 25 años , que atendió a un enfermo positivo a coronavirus en el Hospital de Torrejón de Ardoz (Madrid). Actualmente está aislada en el Hospital Alto Guadalquivir y evoluciona favorablemente.
Esta funcionalidad es sólo para suscriptores
Suscribete
Esta funcionalidad es sólo para registrados
Iniciar sesiónEsta funcionalidad es sólo para suscriptores
Suscribete